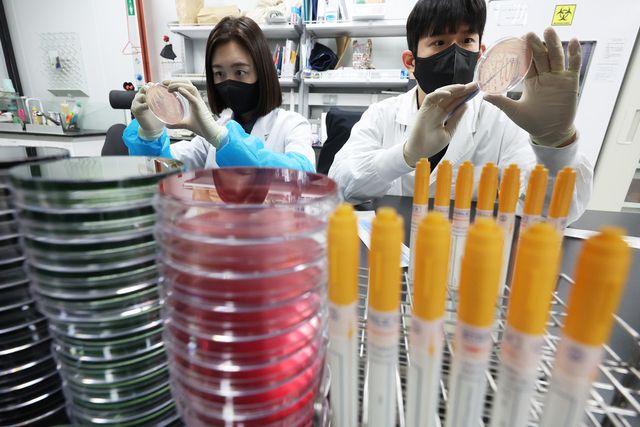
&nbsp;서울시가 여름철 폭염과 폭우로 인한 식중독 발생 위험이 높아지자 시민 안전을 위해 위생 점검을 진행했다.&nbsp; 사진은 경기도 수원시 권선구 경기도보건환경연구원에서 연구원들이 식중독균 배양분리작업을 시연한 모습. (사진=연합뉴스)

[소비자경제] 이동윤 기자 = 여름철 다소비 식품 안전성 확보가 시급한 과제로 떠올랐다.
서울시는 여름철 폭염과 폭우로 인한 식중독 발생 위험이 높아지자 시민 안전을 위해 위생 점검에 나섰다. 서울시는 지난 6~7월 두 달간 냉면·콩국수·보양식 등 여름철 다소비 식품을 취급하는 음식점 1,985곳을 대상으로 집중 점검을 실시했으며, 그 결과 총 22곳의 위반 업소를 적발했다고 18일 밝혔다.
서울시가 최근 5년간(20202024년) 식중독 발생 현황을 분석한 결과, 여름철(68월) 전체 식중독 사례 56건 가운데 절반이 음식점(28건, 50.0%)에서 발생한 것으로 나타났다. 주요 원인은 병원성대장균(21.4%)과 살모넬라(17.9%)였으며, 이는 계절성 식품 위생 관리의 필요성을 보여주는 지표라고 시는 설명했다.
냉면·김밥·보양식 등 집중 단속
이번 점검은 ▴냉면·콩국수·팥빙수 등 여름 인기 메뉴 업소 733곳, ▴달걀을 사용하는 김밥·토스트 업소 668곳, ▴삼계탕 등 보양식 업소 438곳을 중심으로 진행됐다. 또 여름 휴가철 이용객이 몰리는 숙박업소 내 음식점과 야영장·행사장 주변 음식점 146곳도 포함됐다.
점검 항목은 ▴조리장 및 시설 위생 상태 ▴냉동·냉장 제품 보관 온도와 소비기한 준수 여부 ▴식품 표시 기준 및 무신고 제품 사용 여부 ▴종사자 개인위생 상태 ▴위생모 착용 여부 등으로, 위생 관리 전반을 아우르는 내용이었다.
22곳 적발...7곳 영업정지
점검 결과, 총 22곳이 식품위생법을 위반한 것으로 드러났다. 세부적으로는 과태료 부과 7건, 시설개수명령 7건, 직권말소 1건 등 행정조치가 내려졌다. 주요 위반 사례는 ▴건강진단 미실시(1곳) ▴조리장 위생 불량(1곳) ▴위생모 미착용(5곳) ▴음식물 쓰레기통 뚜껑 미설치(7곳) ▴시설물 멸실(1곳) 등이었다.
또한 여름철 다소비 식품에 대한 수거검사도 병행됐다. 팥빙수·냉면·콩국수·식용얼음 108건, 김밥·토스트 등 달걀이 포함된 음식 28건 등 총 136건이 검사 대상이었으며, 이 중 기준치를 초과한 7건은 ‘영업정지’ 처분이 내려졌다.
서울시 관계자는 “최근 폭염과 폭우가 겹치면서 식중독 위험 요인이 크게 늘어난 만큼, 시민들이 자주 찾는 음식점의 위생 안전을 철저히 관리하겠다”며 “앞으로도 지속적인 점검과 검사로 시민 건강을 지켜나갈 것”이라고 밝혔다.
npce@dailycnc.com
Copyright ⓒ 소비자경제신문 무단 전재 및 재배포 금지
본 콘텐츠는 뉴스픽 파트너스에서 공유된 콘텐츠입니다.



